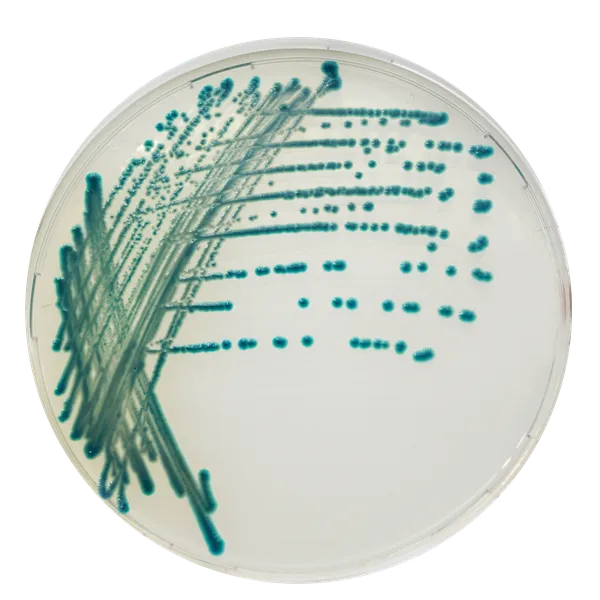
CHROMagar™ Serratia

Hình thái khuẩn lạc

S. marcescens
Xanh lam - xanh lam kim loại
Hiệu năng
Hiệu năng
Serratia species có liên quan đến nhiễm khuẩn bệnh viện. Ở một số quốc gia, Serratia marcescens thường xuyên gắn liền với các vụ dịch trong các đơn vị chăm sóc đặc biệt, đặc biệt là ở các đơn vị sơ sinh và nhi khoa. Giám sát nhiễm khuẩn bệnh viện đòi hỏi khả năng hồi phục hiệu quả các chủng phân lập lâm sàng từ phân, dịch tiết vết thương và các mẫu hô hấp để ngăn ngừa các vấn đề về nhiễm trùng chéo và nhiễm trùng có khả năng gây tử vong. Trong bối cảnh này, CHROMagar™ đã phát triển CHROMagar™ Serratia, một môi trường nuôi cấy hoàn toàn phù hợp để tìm kiếm S. marcescens trong phân.
Thêm vào đó, S. marcescens có khả năng tồn tại từ vài ngày đến vài tháng trên các bề mặt, nước cất và xà phòng rửa tay, khiến nó trở thành một tác nhân gây bệnh quan trọng trong các nhiễm khuẩn bệnh viện và các vụ dịch lẻ tẻ.
Mục đích sử dụng:
CHROMagar™ Serratia là môi trường nuôi cấy chromogen chọn lọc và phân biệt, dùng để phát hiện trực tiếp định tính tình trạng mang mầm bệnh với Serratia marcescens nhằm hỗ trợ phòng ngừa và kiểm soát Serratia marcescens trong các đơn vị chăm sóc đặc biệt (ICU), đặc biệt là sơ sinh. Xét nghiệm được thực hiện với mẫu gạc trực tràng, gạc họng, gạc vết thương và phân từ bệnh nhân để sàng lọc tình trạng mang mầm bệnh Serratia. Nó cũng có thể được sử dụng trong giám sát vệ sinh trong môi trường lâm sàng với lấy mẫu bề mặt. Kết quả có thể được giải thích sau 18-24 giờ ủ hiếu khí ở 35-37 °C.
CHROMagar™ Serratia không nhằm chẩn đoán nhiễm trùng Serratia cũng như không nhằm hướng dẫn hoặc giám sát điều trị nhiễm trùng. Việc thiếu sự phát triển hoặc không có khuẩn lạc trên CHROMagar™ Serratia không loại trừ sự hiện diện của Serratia. Cần có thêm các xét nghiệm nhận dạng, thử nghiệm nhạy cảm, và gõ kiểu dịch tễ học trên các khuẩn lạc nghi ngờ.
3. Độ đặc hiệu cao và giảm khối lượng công việc: Môi trường truyền thống sử dụng để phát hiện S. marcescens như MacConkey Agar có độ đặc hiệu rất kém, tạo ra nhiều kết quả dương tính giả. Bởi vì tất cả các vi khuẩn không lên men lactose có hình dạng tương tự như S. marcescens.
Ngược lại, CHROMagar™ Serratia phát hiện tất cả Serratia (cả những loài có sắc tố hoặc không) và cho phép các kỹ thuật viên tập trung vào các mẫu thực sự bị nhiễm.
4. Màu xanh lục đậm dễ đọc so với các môi trường truyền thống (MacConkey, Blood Agar).
5. Kết quả nhanh chóng đặc biệt hữu ích trong trường hợp bùng phát đột ngột của Serratia marcescens.
Thành phần

Tài liệu kỹ thuật
Công bố khoa học
2021
Evaluation of CHROMagar Serratia agar, a new chromogenic medium for the detection and isolation of Serratia marcescens
? Publication2020
Validation of Colorex™ (CHROMagar™) Serratia agar on WASP™/WASPLab™ in screening for Serratia marcescens in neonatal intensive care units using the ESwab™
? Publication

Xem thêm